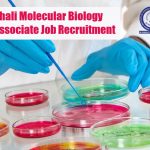
IISER Mohali Molecular Biology Research Associate Job Recruitment IISER Mohali Molecular Biology
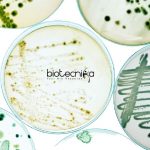
Syngene Executive – Quality Control Microbiology Job Opening Syngene QC Microbiology Job
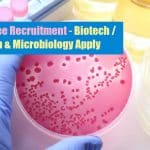
Pfizer Trainee Recruitment – Biotech / Biochem & Microbiology Apply Pfizer Trainee Jobs

Home Search
biology - search results
If you're not happy with the results, please do another search
ICGEB Cancer Project Research Jobs For Biotech/Biochem/Life Science & Microbiology
ICGEB Project Research Jobs For Biotech/Biochem/Life Science & Microbio
ICGEB Project Research Jobs For Biotech/Biochem/Life Science & Microbio. MSc/MTech Microbiology, Biochemistry, Biotechnology, Life Sciences candidates...
Vidyasagar University JRF Jobs For Life Science/ Mol Bio & Microbiology
Vidyasagar University JRF Jobs For Life Science/ Mol Bio & Microbiology
Vidyasagar University JRF Jobs For Life Science/ Mol Bio & Microbiology. MSc degree holders...
CSIR-National Chemical Laboratory Project Recruitment – Biotech & Microbiology Apply
NCL Biotech & Microbiology Jobs - Project Associate Vacancy
NCL Biotech & Microbiology Jobs - Project Associate Vacancy. NCL Pune is hiring MSc/MTech Biotechnology/Microbiology candidates...
IISER Pune Biology & Life Science Research Fellow Recruitment
IISER Pune Biology & Life Science Research Fellow Recruitment
IISER Pune Biology & Life Science Research Fellow Recruitment. IISER Pune is hiring for Life Science...
Crystallography & Molecular Biology Project Assistant at Saha Institute of Nuclear Physics
Saha Institute of Nuclear Physics Project Assistant Job For Life Sciences
Saha Institute of Nuclear Physics Project Assistant Job For Life Sciences. MSc Life Science...
Cell & Molecular Biology Career Path – Job Prospects
Cell & Molecular Biology Career
Cell and Molecular Biology is a field of biology that studies cells and the macromolecules such as DNA, RNA,...
Periyar University Microbiology Research Associate & Assistant Vacancies
Periyar University Microbiology Research Associate & Assistant Vacancies
Periyar University Microbiology Research Associate & Assistant Vacancies. MSc & PhD Microbiology candidates apply for research fellow...
Unilever Research Executive Recruitment – Microbiology / Molecular & Cell Biology Apply
Unilever Research Executive Recruitment - Microbio / Mol & Cell Bio Apply
Unilever Research Executive Recruitment - Microbio / Mol & Cell Bio Apply. MSc...
CSKHPKV JRF Job For Genetic Engineering / Biotech / Molecular Biology
CSKHPKV JRF Job For Genetic Engineering / Biotech / Molecular Biology
CSKHPKV JRF Job For Genetic Engineering / Biotech / Molecular Biology. MSc/MTech candidates are...
IISER Mohali Molecular Biology Research Associate Job Recruitment
IISER Mohali Molecular Biology Research Associate Job Recruitment
IISER Mohali Molecular Biology Research Associate Job Recruitment. Research Associate vacancies for Molecular Biology candidates. PDF jobs....
PGIMER Recruitment – SRF Post For Life Science / Molecular Biology
PGIMER Recruitment - SRF Post For Life Science / Molecular Biology
PGIMER Recruitment - SRF Post For Life Science / Molecular Biology. MSc Life Sciences,...
ICAR-IARI Biochem & Microbiology Recruitment – Applications Invited
ICAR-IARI Biochem & Microbiology Recruitment - Applications Invited
ICAR-IARI Biochem & Microbiology Recruitment - Applications Invited. MSc Microbiology and Biochemistry can apply for research vacancies....
SGPGIMS Stem Cell Project Recruitment For Biotech/ Molecular Biology & Life Science
SGPGIMS Molecular Biology/ Life Science & Biotech JRF Job
SGPGIMS Molecular Biology/ Life Science & Biotech JRF Job. SGPGIMS is recruiting msc candidates for research...
Syngene Executive – Quality Control Microbiology Job Opening
Syngene QC Microbiology Job - Applications Invited Online
Syngene QC Microbiology Job - Applications Invited Online. Syngene MSc Microbiology Job. Check the details on the...
Pfizer Trainee Recruitment – Biotech / Biochem & Microbiology Apply
Pfizer Trainee Jobs - Biotech / Biochem & Microbiology Apply
Pfizer Trainee Jobs - Biotech / Biochem & Microbiology Apply. Pfizer is hiring Biotechnology/ Biochemistry/...